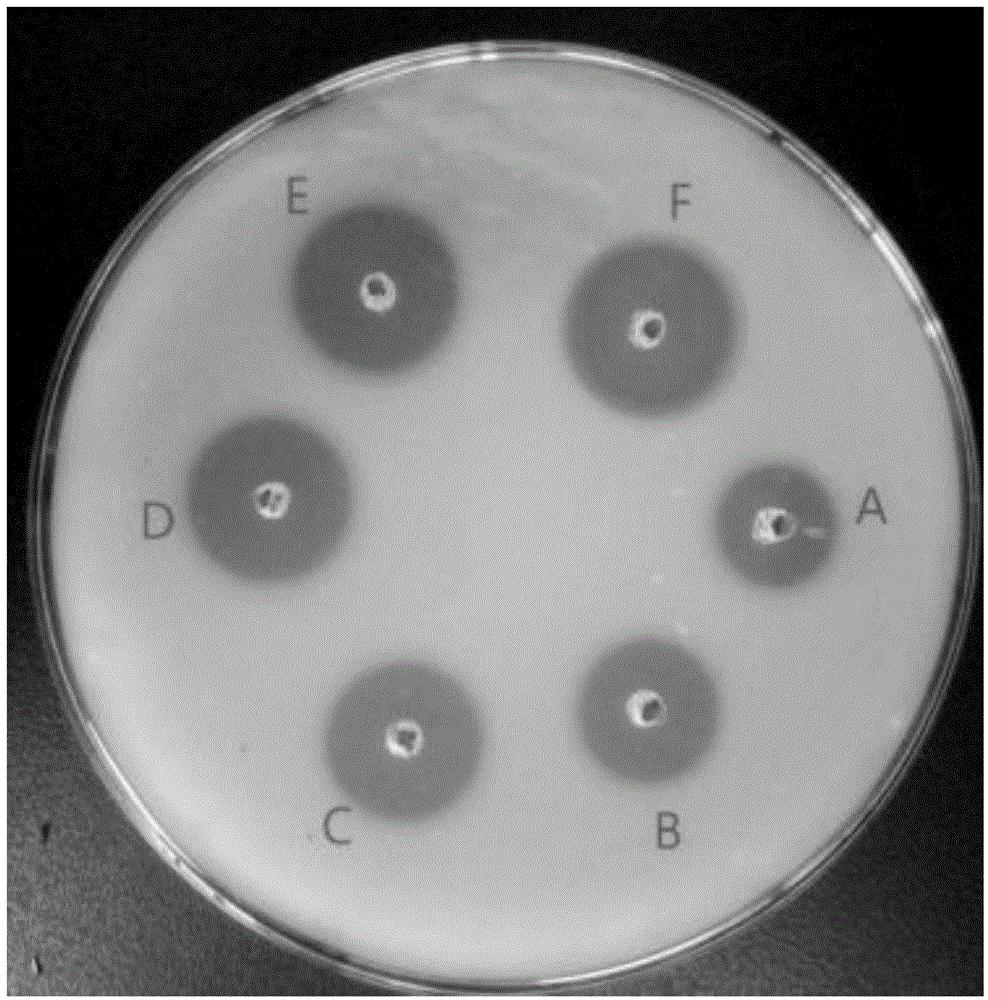
cn109652355a_一种降糖纳豆芽孢杆菌及制备方法和应用在审

纳豆芽孢杆菌

纳豆芽孢杆菌固体发酵研究进展
图片尺寸764x572
纳豆芽孢杆菌
图片尺寸500x500
纳豆的功能性成分主要来自于纳豆菌,别名为 纳豆芽孢杆菌(bacillus
图片尺寸690x460
纳豆芽孢杆菌
图片尺寸600x600
一种具有减脂等功能的纳豆芽孢杆菌bn-sjlh001益生作用及其应用的制作
图片尺寸476x634
芽孢杆菌的功效和作用
图片尺寸388x246
折叠 编辑本段有益种类 折叠 编辑本段生物工程 芽孢杆菌各属拥有各自
图片尺寸500x562
纳豆芽孢杆菌 促消化降氨氮降亚盐缩短养殖周期调水净水水产养殖
图片尺寸800x800
一种产纳豆激酶贝莱斯芽孢杆菌菌株及其应用的制作方法
图片尺寸859x822
芽孢杆菌饲料肥料添加剂生产厂家微元生物纳豆芽孢杆菌
图片尺寸500x710
北极"微生物库"解冻,冰封万年生物复苏,对人类来说意味着啥?
图片尺寸1920x1440
芽孢杆菌的细菌
图片尺寸1200x900
传统大豆发酵食品中纳豆芽孢杆菌的分离及纳豆发酵
图片尺寸551x323
cn109652355a_一种降糖纳豆芽孢杆菌及制备方法和应用在审
图片尺寸988x1000
【原创】细胞培养出现芽孢杆菌污染如何处理?
图片尺寸2272x1704
纳豆芽孢杆菌菌
图片尺寸500x460
枯草芽孢杆菌简称枯草杆菌,顾名思义就是喜欢在枯草中繁殖的一种杆状
图片尺寸1080x718
微生态知识芽孢杆菌的分类及应用
图片尺寸480x360
梭状芽孢杆菌
图片尺寸1080x810
芽孢杆菌,地衣芽孢杆菌,巨大芽孢杆菌,苏云金芽孢杆菌,纳豆芽孢杆菌
图片尺寸401x404